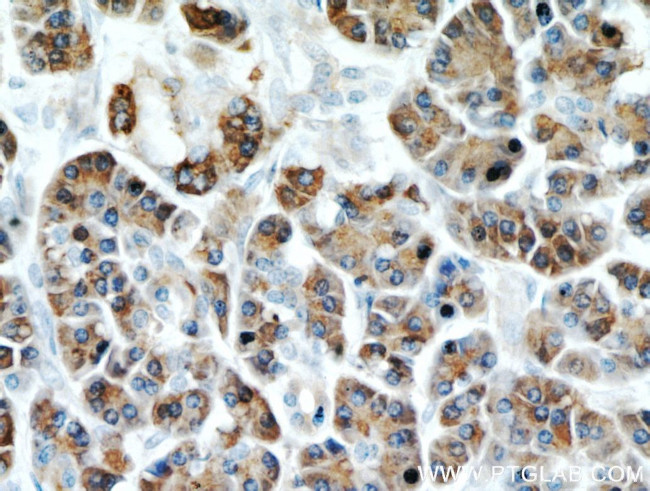
Carboxypeptidase A2 Antibody in Immunohistochemistry (Paraffin) (IHC (P))
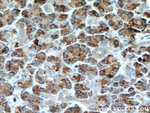
Carboxypeptidase A2 Antibody in Immunohistochemistry (Paraffin) (IHC (P))

Search
Proteintech
Carboxypeptidase A2 Polyclonal Antibody
{{$productOrderCtrl.translations['antibody.pdp.commerceCard.promotion.promotions']}}
{{$productOrderCtrl.translations['antibody.pdp.commerceCard.promotion.viewpromo']}}
{{$productOrderCtrl.translations['antibody.pdp.commerceCard.promotion.promocode']}}: {{promo.promoCode}} {{promo.promoTitle}} {{promo.promoDescription}}. {{$productOrderCtrl.translations['antibody.pdp.commerceCard.promotion.learnmore']}}
产品信息
15626-1-AP
种属反应
已发表种属
宿主/亚型
分类
类型
抗原
偶联物
形式
浓度
纯化类型
保存液
内含物
保存条件
运输条件
产品详细信息
Immunogen sequence: REWVTQATA LWTANKIVSD YGKDPSITSI LDALDIFLLP VTNPDGYVFS QTKNRMWRKT RSKVSGSLCV GVDPNRNWDA GFGGPGASSN PCSDSYHGPS ANSEVEVKSI VDFIKSHGKV KAFITLHSYS QLLMFPYGYK CTKLDDFDEL SEVAQKAAQS LRSLHGTKYK VGPICSVIYQ ASGGSIDWSY DYGIKYSFAF ELRDTGRYGF LLPARQILPT AEETWLGLKA IMEHVRDHPY (184-419 aa encoded by BC014571)
靶标信息
Three different forms of human pancreatic procarboxypeptidase A have been isolated. The encoded protein represents the A2 form, which is a monomeric protein with different biochemical properties from the A1 and A3 forms. The A2 form of pancreatic procarboxypeptidase acts on aromatic C-terminal residues and is a secreted protein.
仅用于科研。不用于诊断过程。未经明确授权不得转售。
生物信息学
蛋白别名: Carboxypeptidase A2; carboxypeptidase A2 (pancreatic); CBPA2; EC 3.4.17; EC 3.4.17.15
基因别名: CPA2
UniProt ID: (Human) P48052, (Mouse) Q504N0
Entrez Gene ID: (Human) 1358, (Rat) 296959, (Mouse) 232680